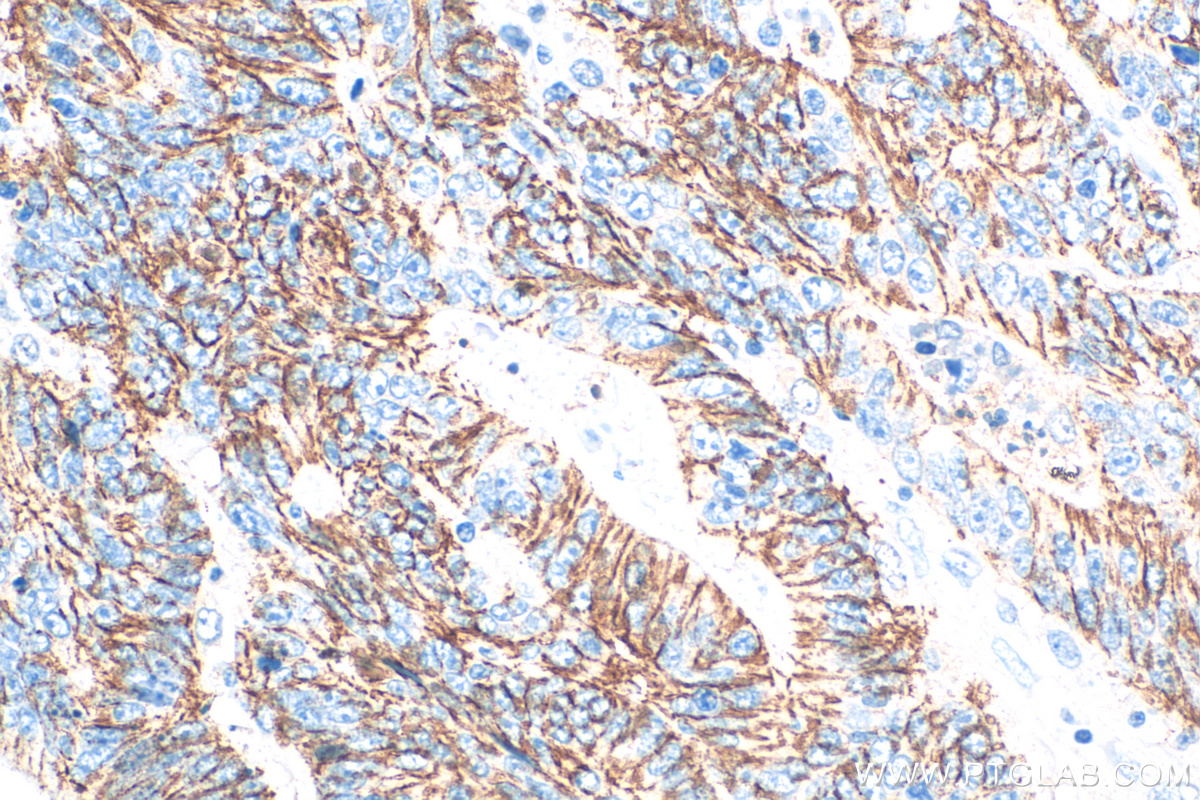
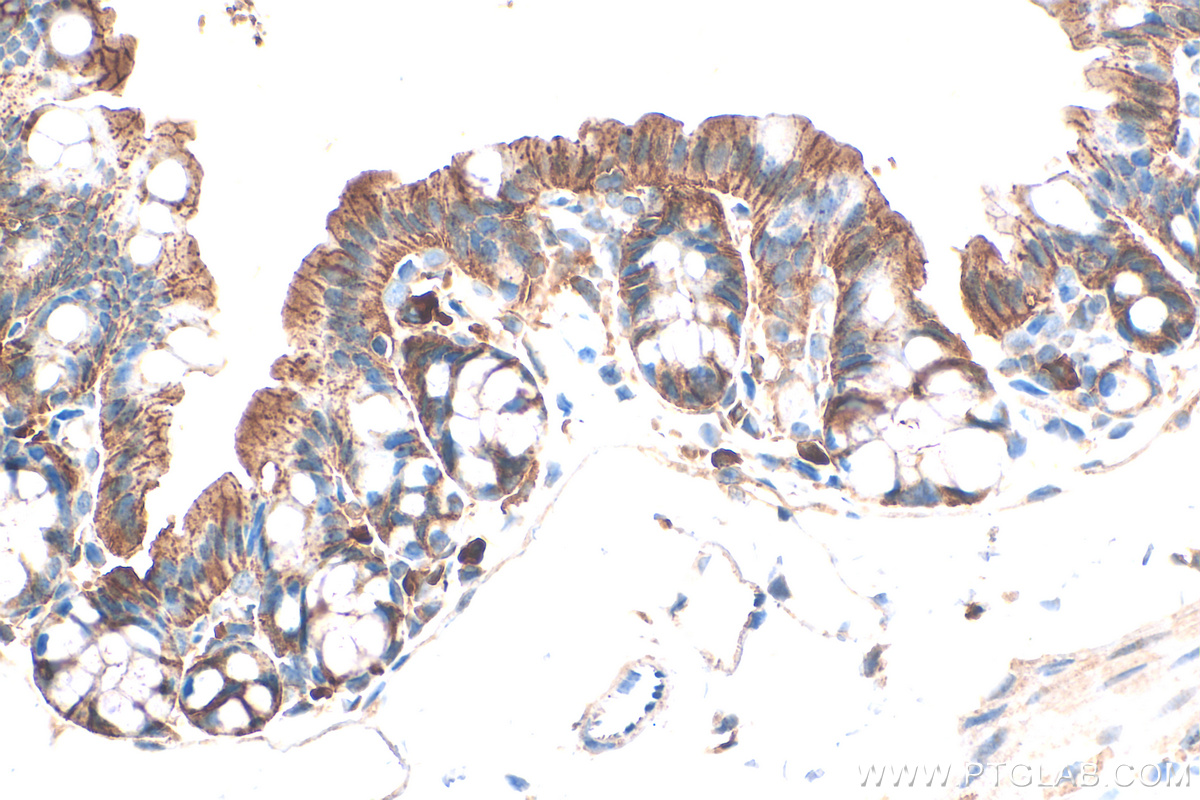

验证数据展示
经过测试的应用
| Positive WB detected in | A431 cells, mouse skin tissue, rat skin tissue, HepG2 cells |
| Positive IHC detected in | human colon cancer tissue, human skin cancer tissue, mouse colon tissue, mouse skin tissue Note: suggested antigen retrieval with TE buffer pH 9.0; (*) Alternatively, antigen retrieval may be performed with citrate buffer pH 6.0 |
| Positive IF/ICC detected in | HaCaT cells, HUVEC cells |
Freshly prepared samples are recommended.
推荐稀释比
| 应用 | 推荐稀释比 |
|---|---|
| Western Blot (WB) | WB : 1:1000-1:6000 |
| Immunohistochemistry (IHC) | IHC : 1:500-1:2000 |
| Immunofluorescence (IF)/ICC | IF/ICC : 1:50-1:500 |
| It is recommended that this reagent should be titrated in each testing system to obtain optimal results. | |
| Sample-dependent, Check data in validation data gallery. | |
产品信息
28674-1-AP targets Claudin 1 in WB, IHC, IF/ICC, ELISA applications and shows reactivity with human, mouse, rat samples.
| 经测试应用 | WB, IHC, IF/ICC, ELISA Application Description |
| 文献引用应用 | WB, IHC, IF |
| 经测试反应性 | human, mouse, rat |
| 文献引用反应性 | human, mouse, rat, pig, canine, bovine, sheep, sus scrofa domesticus (domestic pig) |
| 免疫原 |
CatNo: Ag29269 Product name: Recombinant human Claudin 1 protein Source: e coli.-derived, PGEX-4T Tag: GST Domain: 102-211 aa of BC012471 Sequence: MKCMKCLEDDEVQKMRMAVIGGAIFLLAGLAILVATAWYGNRIVQEFYDPMTPVNARYEFGQALFTGWAAASLCLLGGALLCCSCPRKTTSYPTPRPYPKPAPSSGKDYV 种属同源性预测 |
| 宿主/亚型 | Rabbit / IgG |
| 抗体类别 | Polyclonal |
| 产品类型 | Antibody |
| 全称 | claudin 1 |
| 别名 | Caudin 1, CLDN1, Claudin-1, CLD1, ILVASC |
| 计算分子量 | 211 aa, 23 kDa |
| 观测分子量 | 20-23 kDa |
| GenBank蛋白编号 | BC012471 |
| 基因名称 | Claudin 1 |
| Gene ID (NCBI) | 9076 |
| RRID | AB_2881190 |
| 偶联类型 | Unconjugated |
| 形式 | Liquid |
| 纯化方式 | Antigen affinity purification |
| UNIPROT ID | O95832 |
| 储存缓冲液 | PBS with 0.02% sodium azide and 50% glycerol, pH 7.3. |
| 储存条件 | Store at -20°C. Stable for one year after shipment. Aliquoting is unnecessary for -20oC storage. |
背景介绍
Claudins are a family of proteins that are the most important components of tight junctions, where they establish the paracellular barrier that controls the flow of molecules in the intercellular space between the cells of an epithelium. 23 claudins have been identified. They are small (20-27 kilodalton (kDa)) proteins with similar structures. They have four transmembrane domains, with the N-terminus and the C-terminus in the cytoplasm. Claudin-1 is an integral membrane protein expressed primarily in keratinocytes and normal mammary epithelial cells. Claudin 1 forms tight junctions with other claudin proteins and plays an important role in the intestinal epithelial barrier.
实验方案
| Product Specific Protocols | |
|---|---|
| IF protocol for Claudin 1 antibody 28674-1-AP | Download protocol |
| IHC protocol for Claudin 1 antibody 28674-1-AP | Download protocol |
| WB protocol for Claudin 1 antibody 28674-1-AP | Download protocol |
| Standard Protocols | |
|---|---|
| Click here to view our Standard Protocols |
发表文章
| Species | Application | Title |
|---|---|---|
Microbiome Arula-7 powder improves diarrhea and intestinal epithelial tight junction function associated with its regulation of intestinal flora in calves infected with pathogenic Escherichia coli O1 | ||
J Nanobiotechnology Human umbilical cord mesenchymal stem cells derived exosome shuttling mir-129-5p attenuates inflammatory bowel disease by inhibiting ferroptosis | ||
Matrix Biol Ameloblastin promotes polarization of ameloblast cell lines in a 3-D cell culture system | ||
Int J Biol Macromol Anionic polysaccharides benefit the bioavailability of pork myofibrillar protein gels: Evidence from a perspective of protein absorption and metabolism | ||
Phytomedicine Licorice-regulated gut-joint axis for alleviating collagen-induced rheumatoid arthritis | ||
Biomed Pharmacother Bacterial butyrate mediates the anti-atherosclerotic effect of silybin |